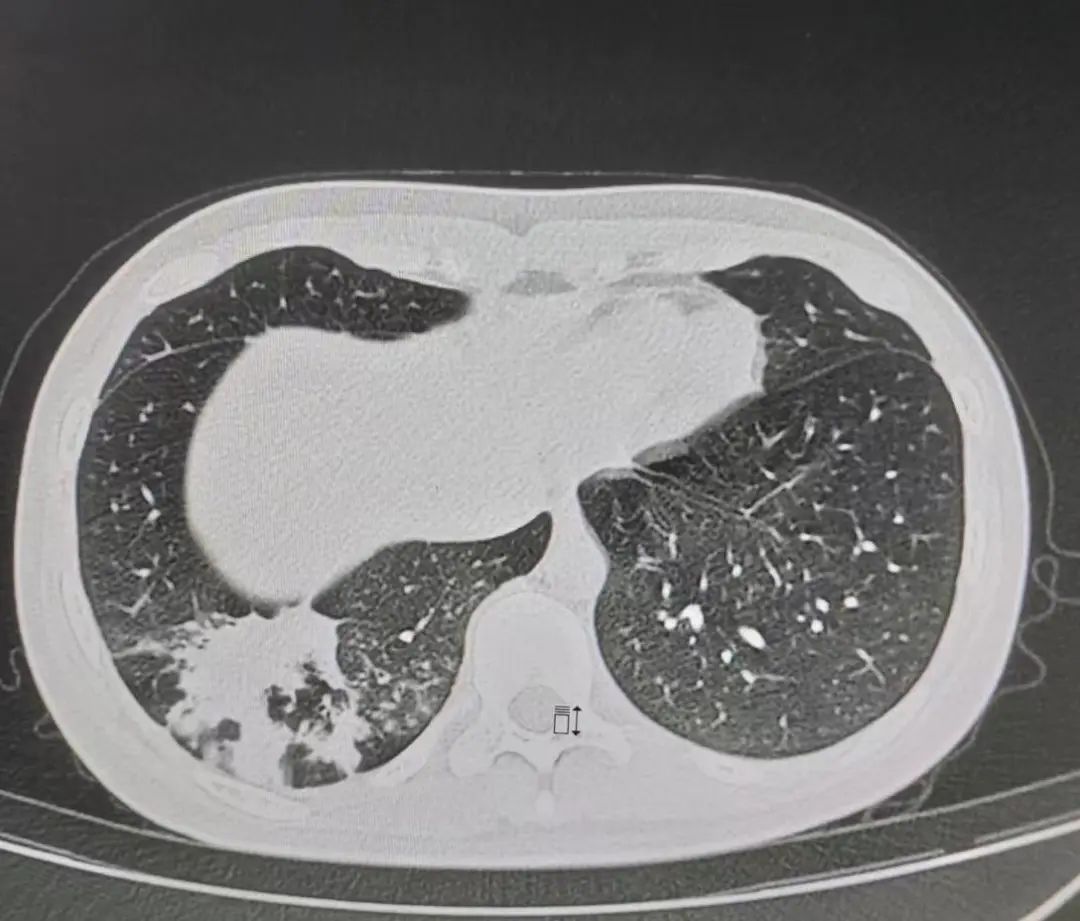
16岁支原体肺炎1-7天表现症状图,儿童确诊支原体肺炎怎么治疗

引言
支原体肺炎是由支原体引起的下呼吸道急性感染性疾病,在学龄儿童及青少年中常见。其发病率逐年上升,耐药形势严峻,给临床治疗带来较大的挑战,严重威胁儿童及青少年的生命和健康。大环内酯类抗菌药物是国内外指南推荐临床治疗小儿肺炎支原体肺炎的首选药物,如阿奇霉素。但我国肺炎支原体对大环内酯类抗菌药物的耐药率远高于其他国家,而对氟喹诺酮类药物和四环素类(如多西环素、奥马环素)抗菌药物敏感。其中氟喹诺酮类药物因有导致儿童和青少年出现软骨发育障碍的可能性,不推荐用于治疗儿童及青少年的支原体肺炎。本例16岁患者确诊为支原体肺炎后,先后给予多种抗菌药物治疗,症状均未好转。该患者的后续治疗又该何去何从…… 呼吸道病原体检测结果示肺炎支原体阳性,先后给予头孢唑肟钠、阿奇霉素、帕拉米韦、多西环素等,症状未好转。
患者是一名16岁的女性,既往体健,无高血压、冠心病、糖尿病史,无肝炎、结核等传染病史,无手术、外伤、输血史,无食物及药物过敏史,无吸烟、饮酒史。久居当地,未到过牧区及疫区。2022年5月底,患者接触感冒病人后出现发热,体温逐渐升至39.9℃,最高可达40.2℃,伴咳嗽、咳痰,为黄粘痰,自行口服头孢类抗菌药物后无改善。2022年6月2日,于他院就诊,进行相关化验检查,行胸部CT示右肺下叶炎症。进行呼吸道病原体检测,结果显示肺炎支原体阳性,确诊为支原体感染。给予复方甲氧那明、头孢唑肟钠、阿奇霉素、清开灵等药物治疗3天,患者仍间断高热,症状未见好转。后更换治疗药物为帕拉米韦、阿莫西林钠克拉维酸钾、赖氨西林、多西环素,患者症状仍未见好转。
进一步行支气管镜检查,明确病因,并排除新型冠状病毒感染可能性
后于6月7日行支气管镜检查,灌洗液NGS结果显示肺炎支原体,白色念珠菌为1*10^2/ml。6月9日,复查血常规,白细胞计数:2.24*10^9/L,淋巴细胞百分比:16.1%,中性粒细胞绝对值:1.59*10^9/L。复查胸部CT,对比6月2日,右肺下叶炎症较前范围增大,新增右侧胸腔少量积液,少量腹水。遂就诊于我院方舱,给予头孢曲松抗感染,排除新型冠状病毒感染可能性后,现为行进一步诊治收入我科(呼吸一科)。

图1 入院治疗前胸部CT
先给予阿奇霉素+多西环素,后调整为奥马环素……病变吸收好转,后出院
于6月11日,患者入院,复查血常规,白细胞计数为2.9*10^9/L。给予阿奇霉素+多西环素+头孢孟多抗感染及升白细胞等综合治疗,患者仍间断高热,精神萎靡不振,并出现皮疹。6月12日,治疗方案调整抗菌药物为奥马环素 0.2g。于6月13日行颈部淋巴结彩超,结果显示双侧颈部淋巴结可见;行锁骨上窝淋巴结彩超,结果显示左侧锁骨上窝淋巴结可见,部分稍大右侧锁骨上窝未见异常肿大淋巴结;行胸腔彩超,结果显示右侧胸腔积液,左侧胸腔未见积液;床旁心脏超声结果显示二、三尖瓣轻度关闭不全。减少奥马环素剂量为0.1g,持续治疗至6月22日。经治疗后患者未诉发热,咳嗽、咳痰明显减轻。于6月21日行胸部CT示右肺下叶散在炎症,建议治疗后复查。对比原片,病变大部分吸收好转,病情好转,于6月23日出院。

图2 入院后体温变化情况
图3 入院治疗后胸部CT
「发热伴咳嗽咳痰」入院,初给予阿奇霉素、多西环素,后更换为奥马环素及其他对症支持治疗——回顾病例,总结经验
病例回顾
1、未满18周岁女性患者,既往体健
2、确诊为 支原体肺炎 ,初给予复方甲氧那明、头孢唑肟钠、阿奇霉素、清开灵等药物,后给予帕拉米韦、阿莫西林钠克拉维酸钾、赖氨西林、多西环素,症状未好转。 遂更换抗菌药物为奥马环素 ,病变大部分吸收好转。后病情好转出院
3、症状:发热,最高可达40.2℃,伴咳嗽、咳痰
4、辅助检查:胸部CT:右肺下叶炎症;支气管镜灌洗液NGS:肺炎支原体阳性,入我院后检出流感嗜血杆菌
治疗过程及心得体会
本病患者持续高热大于10d,肺部影像学提示大片高密度均匀实变,且前期治疗过程中出现影像学表现加重,常规应用抗菌药物治疗无效,属难治性支原体肺炎。大环内酯类、氟喹诺酮类药物、四环素类抗菌药物是治疗支原体肺炎的常用药物。近年来,各国学者研究发现,大环内酯类抗菌药物耐药形势日益严峻,与之相比,氟喹诺酮类药物和四环素类抗菌药物仍然对肺炎支原体保持了良好的体外抗菌活性。本患者未满18周岁,应避免使用氟喹诺酮类药物,先前已静脉滴注多西环素,效果欠佳,故给予新型四环素类抗菌药奥马环素静脉滴注,取得了满意疗效。
专家介绍

蔡志刚
河北医科大学第二医院呼吸与危重症医学一科副主任;主任医师/教授,博士生导师。河北医科大学第二医院呼吸与危重症医学一科副主任;河北省呼吸危重症重点实验室副主任;河北省五一劳动奖章获得者;中华医学会呼吸病学分会介入学组委员;中华预防医学会呼吸病预防与控制专委会委员;中国医师协会呼吸内镜专委会常委;中国医药教育协会介入微创分会常委;CSCO光动力专家委员会委员;河北省急救医学会呼吸专委会主委;河北省预防医学会胸部肿瘤早筛与防治专委会主委;河北省医学会呼吸分会副主委兼介入与肺癌学组组长;河北医师协会呼吸医师分会副主委;河北省中西医结合学会呼吸分会副主委;Thorax中文版编委;Inflammation and cell signaling 编委;国际呼吸杂志常务编委;John Hopkins Hospital 访问学者;University of Maryland Medical Center访问学者;擅长软式/硬质支气管镜、内科胸腔镜、经皮肺穿刺、呼吸危重症抢救等技术,对良恶性气道狭窄、肺癌、肺结节、肺部感染、慢性咳嗽等疾病诊治有深厚造诣。在省内率先开展了硅酮支架置入、Y型覆膜金属支架置入、EBV治疗肺气肿、EBV治疗顽固性气胸、异形支架治疗气管胸膜瘘、打孔支架治疗不能脱机的气管食管瘘、光动力治疗大气道恶性肿瘤等,在省内完成支气管热成型治疗重度哮喘例数最多。积极带头组织县域适宜技术巡讲,推动了河北省呼吸介入的发展。
* 文章仅供医疗卫生相关从业者阅读参考
本文完
责编:Jerry